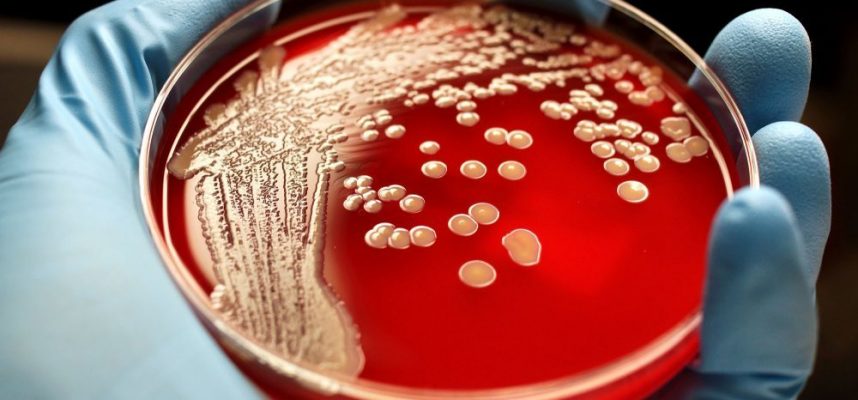
A tudósok 12 000 új típusú mikrobát fedeztek fel

A csírákat növeszteni egy Petri-csészében nagyon egyszerű – törölj le bármit egy vattapamaccsal, hagyd néhány napig meleg szobában, és kész! Új szőrös barátokat szereztél.
De azok a mikrobatípusok, amelyeket egy petri-csészében tenyészthetnek, csak egy kis töredéke a baktériumoknak, az archeáknak és más mikroorganizmusoknak, amelyek a tamponra telepedtek – csak azok, amelyek alkalmasak azokra a körülményekre, amelyekben termesztette őket.
Túlnyomó többségük nem szereti a környezetet, amelyet biztosíthatunk, ezért nem fog engedelmesen nőni egy petri-csészében.
Egy nemzetközi kutatócsoport 12 556 új baktérium- és archaeafajt fedezett fel, amelyeket soha nem termesztettek laboratóriumban egy új metagenomika nevű technikával.
“Több ezer metagenómából származó genomot (MAG) tudtunk rekonstruálni közvetlenül szekvenált környezeti mintákból, mikrobiális tenyésztés nélkül laboratóriumban” – mondta Stephen Knifach, genetikus és a tanulmány szerzője az Egyesült Államok Energiaügyi Minisztériumának közös Genom Intézetében.
“Ami valóban megkülönbözteti ezt a vizsgálatot a korábbiaktól, az az általunk elemzett minták figyelemre méltó ökológiai sokfélesége.”
A csapat hozzáférhetett egy hatalmas adatbázishoz, amely több mint 10 000 metagenómát tartalmaz – ez a kifejezés a környezeti mintákból származó összes genetikai anyagra vonatkozik. Bármely kivonható DNS-t klónozzák, majd a genom apró szálainak felhasználásával szekvenálják, mielőtt a tudósok újra megpróbálnák egyesíteni ezeket a rövid DNS-fragmenseket.
Olyan ez, mintha megpróbálnánk összedolgozni egy összekevert puzzle-t, de a „binning” elnevezésű technikával a csapat 52.515 MAG-ot tudott összeállítani az adatokból – sokuk kiváló minőségű, és mindegyiküknek a genom több mint 50 százaléka teljes.
Nem először fordul elő, hogy a tudósok mikrobákat fedeznek fel metagenomikával – 2018-ban 16 óriási vírust fedeztek fel, 2017-ben pedig új módszerekkel 20 új evolúciós ágat fedeztek fel az élet fáján.
De ebben az új munkában a kutatók számos területről próbáltak elemezni mintákat a mikrobákkal kapcsolatos ismereteink hiányosságainak pótlására.
A hely és a MAG típusainak következetes térképe. (Naifach és mtsai., Nature Biotechnology, 2020).
“Különböző élőhelyekből, beleértve az óceánt és más vízi környezeteket, az emberekhez és állatokhoz kapcsolódó környezetekből, valamint a talajból és más szárazföldi környezetből származó, 10 450 globálisan elterjedt metagenómát végeztünk metagenomikus összeszereléssel és binningolással, 52,515 MAG helyreállítása érdekében.” genetika.
“A katalógus 44 százalékkal bővíti a baktériumok és az archeák ismert filogenetikai sokféleségét.”
Amikor a tudósok megvizsgálták az izolátumok genomját, a korábbi vizsgálatokból származó MAG-okat és az egyes sejtek genomjait, azt találták, hogy az 50 000 MAG-ból 12 556 még soha nem volt szekvenálva.
Most fontos megjegyezni, hogy ezek a genomok nem olyan jók, mint amit a baktériumok és az archeák laboratóriumi termesztésével, majd szekvenálásával kapna. A fúziós folyamat keverheti a genom egyes részeit baktériumfajok között, és a genom fragmentumai gyakran hiányoznak; anélkül, hogy ilyen fajokat laboratóriumban termesztenének, de ez még mindig kiváló módszer a mikrobák kimutatására a körülöttünk lévő világban.
A tanulmány a Nature Biotechnology folyóiratban jelent meg.
Források: Fotó: (Rodolfo Parulan Jr / Getty Images)







